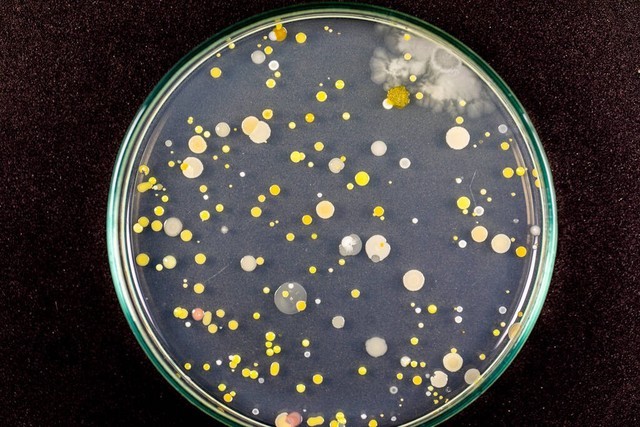

脱氢乙酸钠
脱氢乙酸钠
一、脱氢乙酸钠的简介
脱氢乙酸钠是继苯甲酸钠、尼泊金、山梨酸钾之后又一代新的食品防腐保鲜剂。它通常呈现为白色结晶粉末,无臭无味。脱氢乙酸钠易溶于水、甲醇、丙二醇、甘油等极性溶剂,微溶于乙醇、丙酮和苯,水溶液呈弱碱性。其对霉菌、酵母菌、细菌具有很好的抑制作用,广泛应用于饮料、食品、饲料的加工业,可有效延长存放期,避免霉变损失。

脱氢乙酸钠的作用机理是能够有效渗透到细胞体内,抑制微生物的呼吸作用,从而达到防腐防霉、保鲜保湿等作用。例如,在果蔬贮藏保鲜中,脱氢乙酸钠作为具有杀菌作用的食品添加剂,广泛应用于甜樱桃、树莓、蓝莓、葡萄、鲜切马铃薯和鲜切山药等。它还具有广谱的抗菌能力,耐光耐热效果好,在食品加工过程中不会分解和随水蒸气蒸发。
脱氢乙酸钠的分子式为 C8H7NaO4,摩尔质量 190.13 g/mol,熔点约为 295℃。常温下,在水和乙醇中的溶解度分别为 33g/100ml 和 1g/100ml。其化学性质比较稳定,不易受光受热分解,在 120℃下加热 2 小时仍保持稳定。脱氢乙酸钠具有酚盐所具备的一般性质,可与强氧化性酸剧烈反应,其含有的三羰基甲烷结构能与金属离子发生螯合作用而损害微生物的酶系,所以可以作为防腐剂使用。
二、脱氢乙酸钠的应用领域
(一)食品工业
脱氢乙酸钠在食品工业中有着广泛的应用。在饮料、食品、饲料加工业中,它可延长存放期,避免霉变损失。例如在面包制作过程中,新出炉的糕点添加少量脱氢乙酸钠后,储藏期可以延长到 11 天而不发生霉变。通常面粉不需要发酵时可在和面搅拌的时候加入,若用酵母发酵,则应在发酵后加入。对于烘焙食品来说,脱氢乙酸钠在高温处理后对微生物的生长抑制作用不变,是一种优良的防腐保鲜剂。
在焙烤食品的馅料中,如月饼和点心馅料,由于营养丰富、水分较多,很容易发霉,一般只能存放一周左右。使用脱氢乙酸钠作为防腐剂,则能明显延长馅料的储存期。制作馅料时,可以先用少量的水将脱氢乙酸钠溶解后,拌入馅料中。
在熟肉制品、预制肉制品中,卤肉时在卤水中加入脱氢乙酸钠,可以在产品表面形成保护膜,防止肉发粘、变味、长霉。肉类小吃、凤翅、鸡爪、鸭肫、肉干等,制作时和调味料混合均匀,拌和到产品中。肉肠等加工产品直接加入本品即可,用量为成品的 0.5g/kg,也可以用本品 0.3% 溶液喷淋或浸渍肠衣用于防霉。
(二)果蔬保鲜
脱氢乙酸钠在果蔬贮藏保鲜中也发挥着重要作用。它作为具有杀菌作用的食品添加剂广泛应用于甜樱桃、树莓、蓝莓、葡萄、鲜切马铃薯和鲜切山药等果蔬中。脱氢乙酸钠溶液对芦笋 “镰刀菌枯萎病” 病原菌轮纹镰孢菌 F.concentricum 菌丝生长有抑制作用(90% 抑制率),并抑制产孢和孢子萌发(100% 抑制率);用体积分数 1% 的脱氢乙酸钠浸泡柑橘可使其发病率降低 50%。

(三)其他领域
在化妆品领域,脱氢乙酸钠属于限用物质,无臭,略有特殊味道,可用作防腐剂和防霉剂。用于化妆品和盥洗用品的水溶液防腐剂,全球范围内批准使用,成本低廉、高效,并且广谱抑菌,是一种优异的化妆品防腐剂。
在农药领域,脱氢乙酸钠是一种可应用于蛞蝓、蚂蚁和螨虫的杀虫剂,并且对镰刀菌属和青霉属引起果蔬采后病害有防治作用。
三、脱氢乙酸钠的特点
(一)抗菌范围广
脱氢乙酸钠对细菌、酵母菌、霉菌等多种微生物具有显著的抑制作用。在食品中,这些微生物常常是导致食品腐败变质的主要原因。尤其是对于容易引起食品腐败的酵母菌和霉菌,脱氢乙酸钠的抑制作用最为强大。例如在发酵豆制品、面包、糕点等食品中,脱氢乙酸钠能够有效地抑制霉菌和酵母菌的生长,延长食品的保质期。据研究表明,脱氢乙酸钠对霉菌和酵母的抗菌能力尤强,浓度为 0.1% 的脱氢乙酸可有效抑制霉菌,抑制细菌的有效浓度为 0.4%。抑制引起食品腐败的酵母菌、霉菌的有效浓度为 0.05%-0.1%,一般用量为 0.03%-0.05%。
(二)适用 pH 范围广
脱氢乙酸钠在不同的 pH 条件下都能发挥良好的抑菌作用,这是它的一大特点。与其他常见的防腐剂如双乙酸钠、丙酸钙、山梨酸钾、苯甲酸钠等不同,这些防腐剂一般只在酸性条件下才能发挥作用。而脱氢乙酸钠在酸性、中性、碱性条件下都有抑菌效果,pH 值在 4 - 8 的范围内都比较强。这使得脱氢乙酸钠在各种食品中的应用更加广泛,不受食品酸碱度的限制。例如在复合调味料中,由于成分复杂,pH 值可能会有较大的变化,但脱氢乙酸钠依然能够有效地发挥防腐保鲜作用。蛋黄酱、沙拉酱及其他复合调味料营养丰富,含水量高,极易发霉变酸,加入脱氢乙酸钠 0.05%,能有效遏制霉变发酸。
(三)稳定性强
脱氢乙酸钠对光和热具有很强的稳定性。在食品加工过程中,即使经过高温处理,如在水中煮沸、加热烘烤食品时,它也不会分解、不变质、不挥发。在 120℃加热 2 小时仍不影响其抗菌防腐效力。这一特点使得脱氢乙酸钠在食品加工过程中具有很大的优势,不会因为加工条件的变化而失去防腐保鲜的作用。例如在面包、糕点等需要高温烘焙的食品中,脱氢乙酸钠能够在高温环境下保持稳定,继续发挥抑制微生物生长的作用,从而延长食品的保质期。而且在食品加工过程中,脱氢乙酸钠不会随水蒸气蒸发,能够始终保持在食品中,确保防腐保鲜的效果。
四、脱氢乙酸钠的防腐机理
脱氢乙酸钠的防腐机理主要是通过破坏微生物细胞的亚结构及相关的酶而抑制微生物的生长。
脱氢乙酸钠能够有效渗透到微生物细胞内部,对细胞的亚结构造成破坏。它可以破坏细胞膜的完整性,细胞膜作为微生物细胞的保护屏障,一旦被破坏,细胞内部的物质和能量无法正常运输和代谢,从而导致微生物死亡。例如,脱氢乙酸钠能够改变细胞膜的通透性,使细胞内的重要物质如核酸、蛋白质等泄漏出来,破坏细胞的正常生理功能。
同时,脱氢乙酸钠还能阻断微生物细胞内相关酶的正常功能。酶在微生物的生命活动中起着至关重要的作用,参与各种代谢反应。脱氢乙酸钠与微生物细胞内的酶结合,干扰酶的活性中心,使酶无法正常发挥催化作用,从而阻碍了微生物的新陈代谢。比如,脱氢乙酸钠可以抑制微生物的呼吸酶,使微生物无法进行正常的呼吸作用,进而影响其生长和繁殖。
此外,脱氢乙酸钠还具有降低食品中水分含量的作用。脱氢乙酸钠具有良好的亲水性,可以吸收微生物细胞内的水分,导致细胞脱水。微生物对水分的需求较高,细胞脱水会导致细胞内各种生化反应的受阻,最终导致微生物死亡。
总之,脱氢乙酸钠通过破坏微生物细胞的亚结构及相关酶,以及降低食品中水分含量等多种方式,有效地抑制了微生物的生长,从而起到了防腐保鲜的作用。
五、脱氢乙酸钠的使用方法
脱氢乙酸钠的使用方法灵活多样,具体可根据食品的类型和加工工艺进行选择。
一方面,可以直接加入固体食品中进行混合。例如在制作面包、糕点时,若面粉不需要发酵,可在和面搅拌的时候加入脱氢乙酸钠;若用酵母发酵,则应在发酵后加入。在制作熟肉制品、预制肉制品时,肉肠等加工产品可直接加入本品,用量为成品的 0.5g/kg。此外,在制作调味料时,也可直接将脱氢乙酸钠加入其中,如在蛋黄酱、沙拉酱及其他复合调味料中加入脱氢乙酸钠 0.05%,能有效遏制霉变发酸。
另一方面,脱氢乙酸钠也可配制成溶液进行浸泡、喷淋或表面处理。在制作焙烤食品的馅料时,如月饼和点心馅料,可先用少量的水将脱氢乙酸钠溶解后,拌入馅料中。在制作熟肉制品时,也可以用本品 0.3% 溶液喷淋或浸渍肠衣用于防霉。在腌制蔬菜时,如制作泡菜,可将脱氢乙酸钠用少量水溶解后,均匀倒入缸中。
总之,脱氢乙酸钠的使用方法应根据不同的食品类型和加工工艺进行合理选择,以充分发挥其防腐保鲜的作用,同时要严格控制使用量,确保食品的安全和质量。
六、脱氢乙酸钠的安全性争议
(一)争议双方观点
支持者认为,脱氢乙酸钠在规定的使用范围内是安全的。其安全性已经过大量的科学实验和风险评估,在食品中的添加量非常少,远远低于国家规定的安全限量,因此不会对人体健康造成危害。例如,在面包、糕点、肉制品等食品中,按照规定的剂量添加脱氢乙酸钠,可以有效地延长食品的保质期,同时不会对人体产生不良影响。
反对者则担心,脱氢乙酸钠作为一种化学物质,长期摄入可能会对人体造成潜在危害。例如,可能会引起肝、肾和中枢神经系统的损伤,表现为肝肾功能性减弱,出现惊厥、颤抖、共济失调等神经症状,还可能会引起体重的减少和慢性肺水肿。此外,长期摄入脱氢乙酸钠还可能影响肠道菌群的平衡,而肠道菌群失衡与多种疾病的发生发展密切相关。
(二)科学研究结果
一些研究表明,长期过量摄入脱氢乙酸钠可能会对人体健康造成潜在风险。有研究发现,脱氢乙酸钠可能会影响肠道菌群的平衡。肠道菌群在人体健康中起着重要的作用,它们参与了人体的消化、代谢、免疫等多个生理过程。肠道菌群失衡可能会导致消化不良、免疫力下降、过敏等问题。
还有研究表明,脱氢乙酸钠可能会对肝肾功能造成一定的影响。肝脏和肾脏是人体的重要代谢器官,它们负责清除体内的有害物质。长期摄入脱氢乙酸钠可能会增加肝脏和肾脏的负担,导致肝肾功能损伤。
然而,这些研究结果大多来自于动物实验,其结论并不能直接推论到人类身上。目前并没有直接的证据表明,日常生活中正常食用含有脱氢乙酸钠的食品会对人体健康造成危害。
(三)使用标准及风险
世界卫生组织(WHO)和联合国粮农组织(FAO)也对脱氢乙酸钠的安全性进行了评估,并制定了相应的安全使用标准。根据这些标准,只要食品生产企业严格按照规定使用脱氢乙酸钠,就不会对人体健康造成危害。
但是,在现实生活中,我们很难保证所有食品生产企业都会严格遵守安全使用标准。一些企业为了追求利益最大化,可能会超量使用脱氢乙酸钠,甚至使用不合格的脱氢乙酸钠产品。这种行为无疑增加了食品安全风险,也加剧了消费者对于脱氢乙酸钠的担忧。
为了降低脱氢乙酸钠的使用风险,消费者应该提高食品安全意识,了解食品添加剂的相关知识,学会阅读食品标签,关注食品的配料表和营养成分表。在选择食品时,尽量选择配料表较短、添加剂较少的食品,尤其是对于儿童食品,更要谨慎选择。同时,要选择信誉良好的品牌和商家,购买正规渠道销售的食品,不要贪图便宜,购买价格明显低于市场价的食品,因为这些食品很可能是使用了不合格的原料或添加剂。
七、消费者应对策略
(一)提高食品安全意识
消费者应当充分认识到食品安全的重要性,了解食品添加剂可能带来的潜在风险。脱氢乙酸钠作为一种常见的食品添加剂,虽然在规定范围内使用被认为是相对安全的,但长期过量摄入可能会对人体健康产生不良影响。因此,消费者要时刻保持警惕,关注食品安全问题,不盲目相信食品的宣传和包装,而是通过科学的方法来判断食品的安全性。
(二)学会阅读食品标签
食品标签是消费者了解食品成分的重要途径。在购买食品时,消费者应仔细阅读标签上的配料表和营养成分表,查看是否含有脱氢乙酸钠以及其含量。如果对脱氢乙酸钠比较敏感或者希望减少其摄入,可以选择不含有该添加剂的食品。同时,还可以通过标签了解食品的其他信息,如生产日期、保质期、储存条件等,以便更好地选择新鲜、安全的食品。
(三)选择信誉良好的品牌和商家
信誉良好的品牌和商家通常更加注重产品质量和食品安全。他们会严格遵守国家的相关标准和规定,合理使用食品添加剂,确保产品的安全性。消费者可以通过网络评价、口碑推荐等方式选择信誉良好的品牌和商家,购买正规渠道销售的食品。这样可以降低购买到不合格食品的风险,保障自己和家人的健康。
(四)减少脱氢乙酸钠摄入的方法
选择新鲜食材,自己在家烹饪。减少食用预包装食品的频率,因为预包装食品中可能含有脱氢乙酸钠等添加剂。自己烹饪可以控制食材的新鲜度和添加剂的使用,同时也能享受烹饪的乐趣。购买保质期较短的食品。一般来说,保质期较短的食品中添加的脱氢乙酸钠可能相对较少。消费者可以根据自己的需求和实际情况,选择一些保质期较短的食品,如新鲜的面包、糕点等。注意饮食均衡。多摄入新鲜的水果和蔬菜,增加富含抗氧化剂的食物摄取,如维生素 C、维生素 E 等。这些抗氧化剂可以帮助身体抵抗自由基的伤害,增强身体的抵抗力,减少对脱氢乙酸钠等添加剂的依赖。
总之,消费者在面对脱氢乙酸钠等食品添加剂时,应该保持理性和谨慎,通过提高食品安全意识、学会阅读食品标签、选择信誉良好的品牌和商家以及采取一些减少摄入的方法,来保护自己和家人的健康。
八、脱氢乙酸钠的未来走向
根据国家卫生健康委员会发布的《食品安全国家标准 食品添加剂使用标准》(GB 2760-2024),从 2025 年 2 月 8 日起,脱氢乙酸钠将在我国被全面禁用,包括在淀粉制品、面包、糕点、焙烤食品和馅料等食品中。这一规定的变化体现了我国对食品安全的高度重视,以及对消费者健康的保护。
随着脱氢乙酸钠的禁用,食品行业将面临寻找替代防腐剂的挑战。目前,天然防腐剂如糖醇类、有机酸类以及生物防腐剂等逐渐成为研究的热点。这些替代品以其低毒性、高效性和环保性,有望成为未来食品工业的重要选择。
例如,山梨酸钾作为一种常见的防腐剂,具有较好的抗菌效果,且安全性相对较高。一些企业已经开始探索使用山梨酸钾来替代脱氢乙酸钠,以满足市场需求。此外,一些天然植物提取物也具有一定的防腐作用,如茶多酚、迷迭香提取物等,这些天然防腐剂的应用前景广阔。
然而,替代品的研发和应用并非一蹴而就。一方面,需要进行大量的科学研究和实验,以确保替代品的安全性和有效性。另一方面,企业也需要调整生产工艺和配方,以适应新的防腐剂使用要求。这将需要一定的时间和成本投入。
总之,随着我国对脱氢乙酸钠使用规定的变化,食品行业将迎来新的挑战和机遇。在未来,我们可以期待更加安全、健康的食品防腐剂的出现,为消费者提供更好的食品选择。
标签:


















